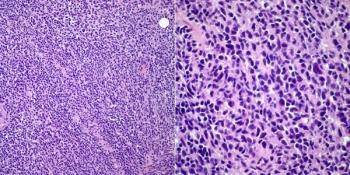

Cesar A. Moran, MD
Advertisement
Articles by Cesar A. Moran, MD
Advertisement
Advertisement
Advertisement
Trending on CancerNetwork
1
FDA Approves Afami-cel in Metastatic Synovial Sarcoma
2
The Moonlight Shift: Dr Joshua Richter on Myeloma, Myths, and the C-Word
3
Current Treatment Landscape of HER2-Positive Metastatic Breast Cancer and Phase 3 Trial Overview
4
How Are Key Lymphoma Data From ASCO and EHA 2026 Shaping Treatment?
5